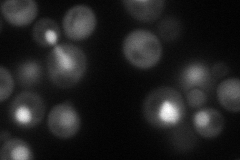
YHR152W
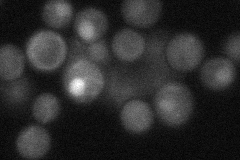
YHR152W
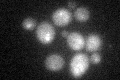
YHR152W
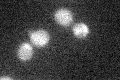
YHR152W

View description
Nucleolar protein of unknown function, positive regulator of mitotic exit; involved in regulating release of Cdc14p from the nucleolus in early anaphase, may play similar role in meiosis
Localization:
Intensity:
Fold change:
Significance:
-
C’ GFP library in SD

below threshold16.53 -
N' NOP1pr-GFP in SD
nucleus78.4101 -
N' TEF2pr-mCherry in SD

nucleus62.4741 -
N' NATIVEpr-GFP in SD
nucleus37.5815 -
N' TEF2pr-VC and Cyto-VN in SD

#N/A0 -
C’ GFP library in SD+DTT
cytosol15.640.94No -
C’ GFP library in SD+H2O2
cytosol16.841.01No -
C’ GFP library in Starvation Media

cytosol17.511.05No -
C’ GFP library on the background of Pup2-DaMP

below threshold -
C’ GFP library on the background of CCT mutant

below threshold16.47810.996134No
